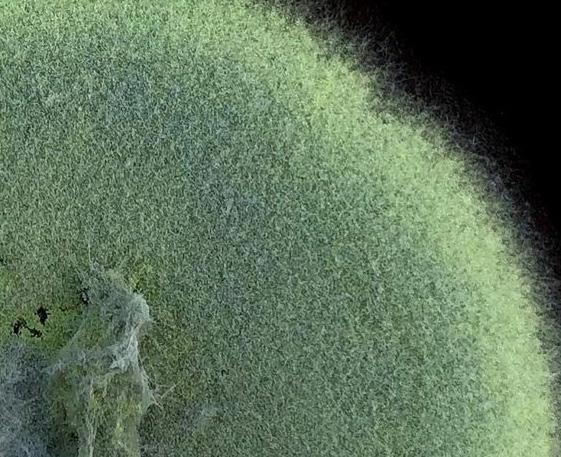

![]()


Format: Whitepaper
Issue : April 15, 2025

1. PREFACE
2. WHITE PAPER SUMMARY
Organization of White Paper
3. ESSENTIAL BACKGROUND on MICROBIOMES
Ancient Relationships
4. HUMAN MICROBIOME FUNCTIONS
Human Gut Microbiota
Microbiome Acquisition and Development
Birth Mode Matters
Cultivating the Microbial Pharmacy
New View of Immunity
The Power of Inflammation
Brain Health from the Gut
5. IMPACTS to the HUMAN MICROBIOME
Unfriendly Foods
Chemicals in the Wrong Place
Additional Stressors on Human Microbiota
6. CROP and SOIL MICROBIOME FUNCTIONS
Crops Feed Their Microbiome
Bacteria Give Nitrogen
Fungi Fetch Phosphorus
Crop Defense Through Partnerships
The Power of Diversity
7. IMPACTS to CROP and SOIL MICROBIOMES
The Oldest Problem
Starving Symbionts
A Great Waste
Feeding Pests and Pathogens
Cultivating Sick Crops
The Nature of Bacteria
8. RESTORING FUNCTION TO MICROBIOMES
A Future for Microbiomes
Implementation Strategy
Framework for Microbiome Recovery
9. GLOSSARY
10. LIST OF REFERENCES

The inspiration for this white paper dates back to a short video series the Center for Food Safety produced in 2018 on the Maoli Oli Study. In this video we highlighted the measurable health impacts that youth farmers (and their immediate community members) experienced during their time working at MA’O Organic Farms.
A wondering sparked: if working at an organic farm, and eating organic fruits and veggies, positively impacted the microbial worlds of human and soil alike, how then were the health of our soil and our bodies intertwined. As a public interest law firm and advocacy organization that roots our work in the science of environmental and human health, the need to understand the importance of these microbial worlds felt urgent. What did the literature say about the link between soil health and human health and how can an understanding of microbiomes explain this connection? How is the industrial food system playing a role in their degradation? Is this a realm we should be protecting?
There is no better popular exploration of this than in The Hidden Half of Nature and so this paper is forever indebted to the courage of Julia Ranney who reached out to co-author Anne Biklé to help bring this long awaited white paper into fruition. This is just the beginning of our journey towards understanding and protecting our microbial world.
Microorganisms are not cuddly, or furry, or iconic. In fact many are reviled. But, we have always lived shoulder to shoulder with the tiniest creatures on Earth. Communities of microorganisms—microbiomes— colonize the surface and crevice of every life form. They live in our mouth, on our skin, and within our gut. They dwell in every soil on the planet. Bacteria even swath and coat the green bodies of our crops inside and out. This is shocking—and necessary. Our well-being, it turns out, depends on the presence of the microbial world, not its absence.
Microbiomes play a vital role in supporting the health of their human and crop hosts. They help keep host metabolism normal, acquire or make nutrients, and spur robust immunity. Without microbes soils could not sustain plant life, cycle nutrients, or store carbon among other functions. Perhaps the real shock is less that we and our crops are covered inside and out with beneficial microbes, and more that humanity’s two great endeavors of agriculture and medicine knowingly and unknowingly harm— but also can help—microbiomes.
What if mainstream practices and products in agriculture and medicine were to align with what microbiomes do for humanity? Crops and livestock could, with help from their microbiomes, secure the nutrients and compounds they need for growth and robust immunity, many of which ripple through to the human diet and into our bodies. Who wouldn’t welcome a food supply rich in the nutrients and compounds we and our gut microbiota need to thrive, but free of health-harming chemicals?
Primary author:
Anne Biklé, independent consultant, biologist, and author on microbiomes, agriculture, and human health.
Contributing authors and reviewers:
Ashley Lukens, PhD, Bill Freese, MA, Julia Ranney.



Microbiomes are integral to the normal health and functioning of their human and crop hosts and all soils. Most human microbiota live in the lowermost part of the gut, and most of the crop microbiome associates with the roots of a plant.




Birth mode as well as diet and exposures to toxins are major influences on the human microbiome. Likewise, the level of soil organic matter and physical and chemical disturbance to soils are chief factors influencing the crop microbiome.

Interactions with a wide diversity of predominately non-pathogenic microbes is necessary for normal immunity, metabolism, and other aspects of physiology in human and crop hosts alike.
The degree to which microbiomes function normally largely stems from symbioses between hosts and their microbiota. In general, when mutual benefits are high, so is functioning. A fiber-rich diet sustains symbioses for human hosts, while root exudates from living plants
Microbiomes are highly responsive to changes in their hosts. They are also resilient provided disturbance and perturbations are low intensity and of short duration.
• The human gut and the roots of crops are functional analogs. Human and crop microbiota support host health through acquiring and transforming nutrients and compounds otherwise unavailable or inaccessible to hosts, particularly those related to normal growth, immunity, and metabolism.
• In normally functioning microbiomes, populations of beneficial microbiota vastly outnumber pathogens, suppressing their numbers in several ways, including physical displacement, resource deprivation, chemical deterrence, and activation of host immunity. This dynamic largely prevents debilitating sickness, high levels of disease, or early death of hosts.
• The high rate of non-medically necessary caesarean births frequently leads to insufficient inoculation of the newborn gut with maternal vaginal microbiota, which in turn impacts normal development of the human digestive and immune systems.
• Low levels of fiber in the human diet malnourish or starve gut microbiota. Antibiotics, pesticides and other industrial chemicals in food and water, and ultra-processed foods also stress human microbiota, compounding the impact of low-fiber diets.
• The physical disruption of plowing and the chemical disruption from intensive and widespread use of fertilizers and pesticides impact crop and soil microbiomes in multiple ways.
Key Outcomes of Impacts to Microbiomes
• The steady increase in the number, intensity, and duration of impacts on human, crop, and soil microbiomes in the last half century has substantially degraded the symbioses under which microbiota and their hosts have co-evolved.
• The impairment of symbioses in turn can drive rapid—and negative—evolutionary changes in microbiomes including increased risk for pathogen colonization, insufficient provisioning of nutrients, and a decrease in microbial metabolites required for health throughout the host lifespan. Less symbiotic microbiomes manifest as abnormal immunity and metabolic processes in people, ineffective defense responses in crops, and disordered nutrient cycling and low levels of organic matter in soils.
• Poorly functioning microbiomes frequently lead to more severe disease and sickness, vastly increasing the need for medical interventions in people, and ever-greater use of, and reliance on fertilizers and pesticides in crops. Attempts to compensate for degraded symbioses often create secondary impacts that cause microbiomes to further deteriorate.
• Routine use of certain products in medicine (e.g., antibiotics) and agriculture (e.g. herbicides) can drive highly undesirable outcomes including reduced efficacy and choice of antibiotics to use against human, plant, and animal pathogens.
• The changes needed to restore human, crop, and soil microbiome functions will require fundamental shifts at societal and personal levels. The following should be considered in developing future strategies, policies, and legislation:
1) Education and acknowledgment that human health and the productivity and longevity of agriculture are intertwined and depend on restoring, and then sustaining symbioses central to normally functioning human and agricultural microbiomes.
2) Modifying existing practices and products and developing new ones is central to microbiome restoration. In most cases practices should take the lead with new products playing a supporting role.
3) Future practices and products that are highly tailored and iterative due to the high responsiveness of microbiomes to variable and rapidly changing host and environmental factors.
4) In the short term, actions should be focused on alleviating acute microbiome symptoms and injury (e.g., use of evidence-based probiotics) to re-build populations of beneficial microbiota and their symbioses with hosts.
5) In the long term, and as a direct consequence of their use, modified and new practices and products should create and maintain conditions in key habitats—the human gut, plant roots, and the soil— that initiate recovery and lead to continued persistence of normally functioning human, crop, and soil microbiomes.

Following a brief overview of microbiomes, readers will find more in-depth information on the way birth mode, the human diet, agricultural practices, and other aspects of our food system impact the way human, crop, and soil microbiomes function. The final section of this white paper provides broad recommendations on how to approach restoring and sustaining normal function to microbiomes. Numerous fields are relevant to microbiomes, chief among them agronomy, plant and crop science, immunology, gastroenterology, and nutrition. Peerreviewed scientific literature and books in these and other areas were consulted to prepare this white paper.
There is a voluminous body of literature on the microbiomes of soils, crops, and humans and a list of references is provided at the end of this document. In general, these references reflect specific information about experimental results and recent discoveries rather than general knowledge about microbiomes. Regarding the terms used in this document, “microbiome” refers specifically to the community of microorganisms on or in a host and their genes. “Microbe” and “microorganism” are more general terms used interchangeably and may or may not emphasize genomic aspects. Communities of microorganisms associated with a specific habitat or part of a host are identified as such, i.e. microbes that live on or in roots are “root microbiota”, those that dwell in the gut are “gut microbes”, and so on. A full list of key terms is provided in the glossary of this document.
Microbiomes are communities of the tinest creatures on Earthbacteria, viruses, fungi, as well as the less familiar archaea and protists - indigenous to a specific host.
Every person, plant, and animal has a unique microbiome, and the same goes for soils across the globe. Despite the integral role microbiomes play at almost every level of life on earth, we have long missed, ignored, or misinterpreted their significance. In part, this is understandable. Microorganisms are invisible and hard to study in their natural habitat. Throughout most of human history people were not aware that these tiny life forms even existed. But by the mid-to late 1800s a series of discoveries illustrated the influence of these diminutive life forms on us. Specific bacteria, viruses, or other microbes were linked to one infectious human disease after another. This knowledge, while of tremendous value, came with a side effect. Well into the 20th century we viewed the entire microbial world through the tarnish of disease and dreaded maladies. Microbiome research has since demonstrated that while we cannot ignore infectious diseases, nor can we demonize the entire microbial world.
We think of our bodies as entirely human, but in fact, each of us is a one-of-a kind chimeric life form—and an ecosystem. Likewise with humanity’s crops and herds of livestock. The multiple landscapes compromised of different habitats within and on the body of every host profoundly influences co-evolution with their respective microbiomes. In recent years, new scientific methods at the genomic and cellular level have uncovered the bias of our minds and the limitations of the naked eye. Not long ago we thought insects comprised most of Earth’s biodiversity, then plants, but now we know that microbes dominate life on Earth.1 Further, bacteria and other microbes are key players in Earth’s carbon and nitrogen cycles. Across every human culture, many a microbe performs the chemistry needed to imbue beloved traditional foods and beverages with their special flavors, smells, and textures, another reminder of the way we and the microbial world swirl around one another.


The symbioses that anchor host-microbiome relationships began in the earliest days of life on Earth well over a billion years ago. Over this immense period of time what began as an optional association between microbes and hosts developed into a symbiotic relationship such that the survival and health of one was impossible without the other.* Communities of microbes in or on a host avoided the dangers in the environment at large and received a steady supply of meals. Hosts gained a variety of functions due to microbial-made molecules and compounds that conferred advantages like new sources of nutrients, the ability to weather environmental extremes, and highly effective defenses to ward off diseases and keep pathogens at bay. These symbiotic relationships led to microbiomes becoming as much a part of a person as their gut and brain. Or for a plant, their roots and leaves. The soil, though not an individual organism, hosts populations of microbes that are the source for crop and other plant microbiomes. Soil-dwelling microbes also function like an external gut in many respects, digesting and breaking down organic matter into usable forms for crops and other land plants.


Microbiomes change over time, in synchrony with the developmental stages of their host. For example, the composition of the seed microbiome is different than that of mature plants, and likewise a newborn’s microbiome is wholly different than that of their parent or sibling. It is worth noting that across crops, livestock, and people, their respective microbiomes needn’t function in some sort of “super” status to confer host health.
Normal status is desirable and sufficient for a host.
Microbiomes highlight another aspect of the microbial world. Pathogens receive a disproportionate amount of our attention relative to non-pathogens. For example, there are about 1,400 known human pathogens.2 In contrast, the estimate of nonpathogenic microbial taxa stands at about 1 million in the human microbiome. In fact, over the course of human history, most of the microbes that associate with humans, crops, and livestock have either beneficial or neutral effects. Research in these areas of agriculture and human biology has expanded more recently, but it still lags behind that on pathogens.
Hosts would be profoundly unhealthy without a microbiome. This is well established in mammals through countless studies on mice bred and raised without microbiota (known as “germ-free mice”).
3 Such mice are riddled with immune system abnormalities and ailments and unable to carry out normal inflammatory responses. For example, germ-free mice have reduced production of the basic mammalian antibody, immunoglobulin A, which makes it easier for pathogens to colonize the gut, lungs, and other mucosal surfaces and cause disease. There is a botanical version of such mice too. An abundance of research shows that plants grown in sterilized soils to which a pathogen is introduced are more prone to disease and related negative health effects than plants grown in unsterilized soils.4 In addition, it has also been shown that as the soil microbial community around a plant’s roots becomes more diverse, infections due to soil pathogens decline. 5
Hosts and microbiomes produce a vast array of molecules and compounds (also called “metabolites”) to communicate with one another. These chemicals activate receptors on and in cells, creating a cascade of effects in host and microbiome alike. Such “crosstalk” profoundly influences host biology and can manifest as normal health or ailments, an increase in disease susceptibility—and even— the return of normal health.
Several factors enable or scuttle crosstalk between crops and their microbiomes. For example, gut microbiota transform the fiber and phytochemicals in whole plant foods into compounds that signal immune cells to develop into types that quell inflammation as needed. In contrast, a low-fiber diet leads to lower levels of the microbial metabolites foundational to effective crosstalk with immune cells. As a consequence, host susceptibility to a range of diseases and ailments of the gut, brain, and immune system can increase.
Communities of microbes live all over the skin and inside the human body in different habitats that reflect physical, nutritional, and other conditions. Lungs are moist and coated with protective mucus in contrast to the relatively dry conditions on our feet, arms, and legs. A person’s mouth is a dynamic habitat, undergoing constant physical and chemical changes due to foods, liquids, and oral health practices. Of all the places in our bodies however, most of the interactions and crosstalk with the human microbiome occur in the gut. This isn’t surprising for a reason to which we can all relate: food. Much of the human microbiome occupies our approximately 22-foot long digestive tract. Habitat conditions improve dramatically downstream of the stomach with the last five feet, the underappreciated colon, providing an especially favorable place for human microbiota.
Bacteria are the most studied members of the human microbiome. Estimates of their abundance range from approximately as many as our own cells (40 trillion) up to about 30 percent more depending on age, gender, and other factors. This estimate, however, doesn’t include fungi, viruses, and other types of microbes. Fold in their numbers and microbial cells easily surpass our own.

Most consequential about these microbial numbers is the enormous collective genome they bring into a host. Bacteria alone contribute roughly 2,000,000 genes, about a 100-fold increase over our approximately 23,000 genes.7 Add in the genes of other human microbiota and the sum total swamps our own—by about a thousandfold. 8


It bears repeating that all these microbiota do things in our bodies. They can act on their own, in combination with other microbes and environmental factors, and in concert with, or counter to human biology. For example, communities of gut microbiota do what human cells cannot—produce the array of enzymes needed to break down fiber and phytochemicals in whole plant foods of the human diet.* Consequently, these dietary components move through the digestive system relatively intact until they reach the bottom of the gut. This provides colon-dwelling populations with a steady, reliable food source to which they are adapted. One colon-dweller, a bacterium with a mouthful of a name—Bacteroides thetaiotaomicron—possesses a genome capable of producing about 260 different enzymes for breaking down whole plant foods. Our own genes produce a paltry number of plant-degrading enzymes, only about 20.9 To B. thetaiotaomicron and the hundreds of other bacterial species specializing in and phytochemicals, the human colon is like tranquil grazing pastures.

Our dependency on the genomic functions of our microbiota calls for an update to the familiar adage, “you are what you eat.” We are far more a product of what gut microbiota make with what we eat.

Colonic-dwelling microbiota, for example, produce about a third, to as much as 40 percent of all metabolites circulating in the human body. These metabolites (as well as cellular components of gut microbiota) are vital to normal crosstalk with endocrine, immune, and nerve cells that are part of the digestive tract as well as with the cells of other organ systems.




The human immune system plays a major role in determining the composition of gut microbial communities. One of the most important findings emerging from human microbiome research is that normal development of the immune system relies on interactions with gut microbiota, and specifically, a wide diversity of symbiotic and non-pathogenic microbes.
This is not surprising – about 70 percent of human immune cells reside in gut tissue.11
Further, communication between immune cells and gut microbiota is crucial to the primary task of the immune system—orchestrating a balanced inflammation response. Too much inflammation and healthy cells and tissues take a hit. Too little inflammation allows pathogens to gain a foothold, or ailments such as cancer to occur.

The most important window for exposure to beneficial microbes is from birth through the first several years of life. These initial encounters with the microbial world teach and guide the human immune system to know friend from foe, and as a consequence, help determine future inflammation levels in a host and their body-wide effects. This process builds tolerance and acceptance for the trillions of microbes comprising the infant and early childhood microbiome as well as its changing composition over the rest of the human lifespan. It is also but one instance of how gut microbiota wield profound influence over tissues and organs far from the gut.
Research points to birth mode as a major factor in the development and composition of the human microbiome. Maternal biology changes ecological conditions along the birth canal through increasing production of vaginal secretions that nourish Bifidobacterium and Lactobacillus bacteria in the hours before birth and their numbers soar. Species from these two genera are crucial for infant health in the hours and weeks after birth and in the months before solid foods. As a baby slowly moves through the birth canal immense numbers of Bifidobacterium and Lactobacillus enter their mouth and nose, and soon thereafter reach the digestive tract. During the final phase of birth, a dab of maternal feces seeds the baby with additional types of human gut microbiota. Once vaginally-birthed babies emerge into the world they are inoculated inside and out with the inaugural crop of microbes needed for life outside of the womb.


The microbiomes of babies born via caesarean (C-section) differ from those of babies born vaginally. The United States stands out in this context because we have among the highest rates of nonmedically necessary caesarean (C-section) births.12 Bypassing the birth canal changes the initial gut microbiota composition of such newborns. In general they acquire fewer Bifidobacterium and Lactobacillus bacterial species and more microbes associated with skin and the external environment. Gut microbiota diversity of C-section birthed babies is also generally lower than that of infants born vaginally.
These differences matter. In the months following birth, interactions between a newborn’s immune cells and maternal microbiota normally acquired through vaginal birth play a major role in the subsequent development of human immunity. Missing this early-in-life window of time increases the risk of certain diseases and health conditions in C-section babies later in life, including asthma, eczema, and food allergies. 13 Risk of obesity and overweight is also greater. In one study, infants 6 to 12 months old with low Bifidobacterium populations were overweight by age 7. 14 Low levels of bifidobacteria are also correlated with a diminished vaccine response later in life as well as abnormalities in fatty acid and bile acid metabolism. 15
Contrary
to what most people think, breastmilk is not solely for young infants.
It nourishes Bifidobacterium infantis, one of the first bacterial members of the human microbiome in infants born vaginally. Human infants cannot make the enzymes needed to digest the complex sugars found in human milk, of which there are over 200 types. Fortunately, B. infantis does make many of the requisite enzymes.16 This bacterium, along with other initial Bifidobacterium and Lactobacillus colonizers, thrives on human milk sugars, and human infants thrive on the microbial metabolites produced from the sugars, especially short-chain fatty acids (SCFAs). 17 These compounds are among the most intensively researched microbial metabolites. In infants, SCFAs help gutassociated immune cells not only recognize, but tolerate human gut symbionts. 18 In addition, a baby’s gut cells have particularly high energy demands, and SCFAs are crucial to fueling the gut’s nutrient assimilation, immune, and endocrine activities throughout the digestive tract. 19 Sufficient energy for gut cells, in turn, serves another fundamental purpose: ensuring the gut forms a stout barrier between its contents—like pathogens, toxins, and partially digested food—and the rest of the body. Keeping gut contents contained is essential to avoid triggering needless inflammation elsewhere in the body.
Once a baby is weaned, SCFAs continue to play significant roles in host health. These compounds and many others are made in the least-loved part of the digestive tract: the colon. Far from popular depictions assigning it to garbage can status in need of regular cleaning, the human colon is more akin to a living and personalized medicine cabinet. Key to this remarkable property are the colonic-dwelling bacteria and their preferred energy source—the fiber and phytochemicals found in whole plant foods of the human diet. Together, they make the human colon one of the most transformative parts of the body—and help explain why gut conditions figure so prominently in disease and maladies elsewhere in the body.


The three most abundant SCFAs that colonicdwelling microbiota make are butyrate, acetate and propionate. 20 They are instrumental to a balanced inflammatory response—not too much, not too little, and at the right time. Each has primary effects. In general, butyrate strongly influences gut function, whereas acetate and propionate are absorbed and utilized in peripheral tissues and the liver, respectively.
The effects of butyrate on host health have been investigated through animal models, human trials, and cell and tissue culture experiments. Butyrate strongly influences the normal differentiation and deployment of different types of gut-associated immune cells.*,21 Low colonic butyrate levels, however, can drive the development of proinflammatory immune cells in the gut and have been linked to Crohn’s disease and ulcerative colitis (either of which are also known as “inflammatory bowel disease.”) In addition, low levels of butyrate can also impair the ability of the gut wall to function as an effective barrier. 22
Butyrate also triggers gut-associated endocrine cells to release hormones central to normal blood sugar levels, feelings of satiety, and fat storage. 23 Glucagonlike peptide-1 (GLP-1) is one such hormone. During and immediately after meal, SCFAs cause levels of GLP-1 to rise, reach the brain, and soon thereafter a person feels full and stops eating.*

Research also suggests that higher levels of gut-generated SCFAs are neuroprotective, helping to prevent the onset of Parkinson’s disease 24 and other neurodegenerative conditions, including multiple sclerosis, Alzheimer’s disease, and some forms of depression. 25

Research on high-fiber diets known to nourish SCFA-producing gut microbiota have shown improvements in health conditions and diseases characterized by excessive chronic inflammation including those affecting the cardiovascular system (e.g. hypertension), respiratory system (e.g. asthma), metabolism (e.g. nonalcoholic fatty liver disease), and mental health.26
The insights and discoveries steadily pouring forth from the labs of microbiome scientists and researchers provide an abundance of evidence that a pathogen-centric view of the microbial world fails as the sole paradigm for human health. Effective, robust human immunity relies on non-pathogenic and neutral microbes—the dominant life forms on Earth. The view emerging from this realization is grander and more complex than immunologists and many others could have imagined just a few decades ago.
A person’s health, and thus their quality of life depends on an immune system capable of recognizing all microbes, those from maternal sources as well as from environmental sources like food and soils.
This is a lot to take in, but also immensely important if we are to restore the basic functions of microbiomes, both in the human population and those we need for agriculture. There is an inestimable value to ensuring that immune cells communicate with a diversity of non-pathogenic microbes from the moment of birth onward and for the rest of a person’s life. We need to let human microbiota hold the reins and mentor the immune system, especially early in life. From deep within the gut, they can imbue the host immune system with the intelligence and skills to know which microbes to feed and tend, and which to keep out and cull. Mastering this balance is dynamic and nuanced for host and microbiome alike. However, reducing the exposure of healthy tissues and organs to low-level inflammation is a key factor in preventing the onset of common chronic diseases that burden many in America today. 27
The result of malnourishing SCFA-generating gut microbiota now roosts in many of us—a slew of inflammation-related health conditions and chronic diseases. This situation comes into focus considering that the gut wall is just one cell thick. As in the infant gut, colonic cells in later life rely on the same SCFA, butyrate, for most of their energy. When the butyrate supply plummets, colon cells have a hard time staying snug against one another, nor can they produce the large amounts of mucus needed to backstop their one-cell thickness and protect the colon wall. This allows gut contents to escape into the bloodstream and reach places they are never supposed to be—like the brain, lungs, and liver. In response, the immune system ramps up inflammation. So long as colon cells remain malnourished and the gut barrier compromised, the risk of systemic inflammation and related ailments persists.


Human gut microbiota and their origins in maternal ecology and the natural environment bear on a uniquely human trait, our complex brain. It has long been noted that neurological conditions and gut dysfunctions often co-occur. This is the case for early-in-life conditions like autism, as well as ailments that strike later in life, such as Alzheimer’s disease, Parkinson’s disease and some forms of depression. Research in this area increasingly points to the gut, rather than the brain as the source of such maladies. 28
As discussed previously, gut microbiota-made SCFAs help to ensure a balanced immune response. In contrast too few SCFAs leads to the opposite, gut-associated pro-inflammatory immune cells. Research points to these pro-inflammatory cells exiting the gut and entering the brain where they activate inflammation in the brain’s own immune cells.*29 This outcome, in turn, is thought to increase the risk for brain-related diseases and conditions in which inflammation plays a role.
The neurotransmitter serotonin is most often associated with brain function and mood, but it appears the gut has its own version of ailments related to serotonin production. Specialized endocrine cells in the gut wall make, store, and release serotonin which can be as much as 90 percent of the serotonin supply in the entire body.30 In the gut, serotonin underpins basic functions like orchestrating the suite of activities needed to keep gut contents moving along day in and day out. Evidence from studies of animal models and human cell lines has shown that gut microbiotagenerated SCFAs figure into this connection—they stimulate endocrine cells in the gut wall to produce serotonin.31 But, when SCFA-generating microbiota populations are low, so are serotonin levels, which leads to an unhappy gut and motility dysfunctions such as constipation.



These and other gut-brain linkages are generating a new appreciation of the human gut as a sensory organ and its other name—”second brain.”32
This area of research is one of the most intriguing and complex within the human microbiome and helps explain the “gut feelings” we have all likely experienced.
Human health reflects a constellation of factors including a person’s genes, exposure to environmental toxins and unsafe environments as well as access to health care. Longevity is one measure of health, and in this context people in the United States are living longer than they did in 1900. 33 But by another measure we are not doing so well. Chronic diseases shorten the number of years of healthy life and lead to 7 of 10 Americans dying younger than they should. 34 Such diseases live up to their namesake, “chronic”, as they can last for decades and strike in young, middle, or old age. Once acquired, they are rarely curable.
Persistent, low-level inflammation plays a role in many chronic diseases and ailments, with the strongest evidence for metabolic syndrome*, type 2 diabetes and cardiovascular disease.35 Other common ailments linked to abnormal inflammation include asthma, eczema, depression, irritable bowel disease, neurological disorders, obesity and some cancers. Research points to disrupted microbiomes as a contributing factor in a number of chronic diseases although the chain of causality is not always clear or completely understood.

Evidence from numerous studies on people and mice reveal that rapid shifts in the composition of gut microbiota can occur within hours or days of a change in the host diet. 36 Pair this finding with the steady creep of heavily processed plant and animal foods into the America diet over the latter half of the 20th century and it appears that we have slowly been starving colonic-dwelling microbiota. Unfortunately, depriving them of the very thing they need—a diversity of fiber and phytochemicals found in whole plant foods—reduces their production of the metabolites we need. Notably, the immunemodulating SCFAs made in the colon and critical to normal human biology.
The dramatic shift in the American diet mirrors changes in agricultural practices over the same time period.
We
replaced
one
of
the main sources of nourishment for soil microbiota—fiber-rich food like mulches, composts, and manures— with processed versions of nutrients, notably highly soluble fertilizers. This in turn has unleashed a cascade of negative effects on soil health and crop microbiomes.
In the history of agriculture and food that impacted the gut microbiome
The pace of human gut microbiota malnourishment quickened with widespread industrialization of agriculture after World War II. Crops were increasingly grown to provide a burgeoning food industry with a reliable supply of ingredients to make new food products. Americans ate few of these products initially, but over time the feedstock of ingredients grew in volume and diversified alongside ever-more sophisticated product formulations and manufacturing methods. For example, in 1998 just over 10,000 new food and beverage products were introduced—by 2016 that number had doubled. 37
A closer look at this linked-at-the hip shift in agriculture and the American diet proves illuminating relative to human gut microbiota. In 1997 we ate about the same amount of carbs as we did in 1909. 38 But, there was a significant difference. The type of carbohydrates. Food manufacturers cherrypicked the sugary components—the simple carbs—to use in ultra-processed food products. The non-sugary parts, among them fiber and phytochemicals, rarely made it into a final product.*

Today, the industrial-scale of operations and ever-more sophisticated food processing methods have left no grain, bean, fruit, vegetable, nut, seed, leaf, or shoot untouched.
Inside the walls of factories far from the light of day, tons of whole plant foods are macerated, deconstructed, and stripped of myriad types of fiber and phytochemicals on which the human gut microbiota relies. The resultant mush is then suffused with substances and chemicals, extruded into various shapes, and put inside of colorful packaging. In the United States we consume more ultraprocessed foods than any other country. They comprise nearly 60 percent of our calories.39 This is a Titanic-sized dietary shift not only for us, but also human gut microbiota.
In research on indigenous populations still subsisting largely on traditional diets rich in unrefined carbohydrates and phytochemicals illustrate the shortcomings of ultra-processed foods. Studies of gut microbiota composition in the Hadza, a Tanzanian hunter-gatherer society and others reveal stark differences with residents of Western countries.40 Their gut microbiota populations are both more diverse and especially rich in bacteria that specialize in converting fiber and phytochemicals into SCFAs and other metabolites. In addition, the researchers note that immune disorders and other diet-related chronic diseases plaguing Western countries are rare among such populations.
Using a mouse model endowed with human gut microbiota researchers investigated the effects of fiber deprivation. In experiments with four successive generations of mice fed a diet of diminishing amounts of fiber, some of the fiberdependent taxa were gone by the last generation. Overall gut microbiota diversity had also decreased. Even switching mice held aside from each generation to a high fiber diet did not restore the missing taxa. However, if the missing human symbionts were re-introduced to the mice, simultaneous with the mice resuming a high fiber diet, the symbionts re-established their populations.41 Although this research is on mice, it suggests the possibility—and effectiveness—of the host diet to restore gut microbiota communities, and thus their metabolites and functions in human biology.

The steady increase in the levels and types of pesticides in American agriculture, particularly since the mid-20th century remains an underresearched area of human health relative to our microbiome. The herbicide, glyphosate (and glyphosate-based products) are particularly concerning in this regard. Following the introduction of crops genetically modified to tolerate glyphosate in 1996 use of the herbicide increased substantially.42 By 2000 glyphosate was the most applied weed killer in the United States on a per pound basis of active ingredients. By about 2005 use had doubled, and by 2016 use had tripled to 304 million pounds, 92% of which was applied on farms.43 These usage figures far exceeded those of any other weed killer at the time.45 The introduction of additional glyphosate-tolerant crops—corn, sugar beets, canola, cotton, and alfalfa—beyond the initial one (soybeans) is largely responsible for these trends. Today, glyphosate is the most commonly used herbicide in the U.S. as well as globally.
Glyphosate has since been found in food (honey, beef, fruits, vegetables, and grains) and beverages (juice, beer, and wine). The herbicide or its main, toxic breakdown product was also found in rain, soil, surface waters, and groundwater through extensive sampling that occurred from 2001 to 2010 across 38 states.46 Through these and other routes, such as dermal absorption and inhalation of spray mist, glyphosate is also in people— farmers, as well as over half of the general public, including children. 47

Glyphosate kills non-resistant weeds through blocking the seven-step shikimate pathway, a linked set of biochemical reactions yielding intermediate compounds and several amino acids. The absence of the shikimate pathway in people (and other vertebrates) is frequently invoked to assert that glyphosate poses negligible harm to human health. This assertion, however, overlooks that bacteria and fungi, including members of human, crop, and soil microbiomes possess shikimate pathway biochemistry and are thus potentially impacted. Nor does it consider a well-known feature of community ecology—that loss or injury of one or several members often impairs overall community functioning.
It bears repeating that human gut microbiota produce about a third to as much as 40 percent of all metabolites in their host, many of which are integral to normal function of immune, nervous, and endocrine cells in the gut wall specifically, and human biology generally.
The effects of glyphosate on human health through altering microbiome composition was little, if at all, considered in the late 1990s when use on food crops began to rapidly increase. But, a body of evidence has since emerged from more recent research which suggests that altered microbiome composition is a likely route by which glyphosate impacts human health. A range of experimental settings and subjects including animal models, cell and culture studies as well as genomic analyses show that glyphosate can alter the composition of animal microbiomes, in particular bacterial communities adapted to the host gut. Genomic research, for example, found that 54 percent of microbiota considered “core” to the human microbiome were susceptible to glyphosate and its main, toxic metabolite (AMPA).48 Several rat studies show that low-dose oral exposure to glyphosate and/or Roundup enriches the gut microbiome in Bacteroidetes phylum bacteria and reduces levels of Firmicutes taxa such as Lactobacillus—results observed in both adult rats49 and pups exposed perinatally.50
In addition, several reviews point to pesticide exposure, including to glyphosate, leading to changes in host microbiota and subsequent altered microbial metabolites. 51 In general, the metabolites of bacteria vulnerable to glyphosate can decrease, while metabolites from bacteria able to resist glyphosate can increase. These changes can affect human health in various ways from compromising gut wall integrity to interfering with a range of microbially-mediated communication along the gutbrain axis.
For example, in research using a mouse model, high oral doses of glyphosate led to a marked decrease in populations of several species of the common bacterial gut symbiont Lactobacillus followed by anxiety and other depressive behaviors in the mice.52 These behavioral changes in mice were attributed to insufficient SCFA production leading to increased permeability of the gut wall and subsequent escape of toxins, including glyphosate, from the gut into general circulation. Impaired gutbrain communication along the vagus nerve due to insufficient SCFAs was also considered a potential mechanism.

In addition to glyphosate contamination of drinking water and various foods, another exposure route in people may be through the routine practice of spraying glyphosate on wheat shortly before harvest. While some people attribute gut dysfunction and related symptoms to the gluten in wheat, glyphosate residue in food products containing wheat may well be a contributing and little-appreciated factor. 53
When antibiotics made their debut in human medicine a little over 80 years ago they earned the moniker “wonder drugs.” They were as life-changing for doctors and patients as the first pesticides were for farmers. Initially both seemed poised to deliver on two of humanity’s topline goals—saving lives and producing food.
Many of the early antibiotics used in human medicine were derived from anti-microbial compounds that soil bacteria make to send stronglyworded “stay away” messages directed at other microbes seeking to encroach on space, nutrients, or other resources. In an environment like soils, filled with numerous different life forms, many of which are actual or potential partners, non-lethal interactions are paramount— and generally highly effective. In contrast, we concentrate antibiotics many times over and use extraordinary doses over long, sustained time periods. This approach kills the targeted pathogen plus a lot of other microbes, including members of the human microbiome. Some bacteria, however, either possess or develop ways to sidestep the lethal effects of antibiotics. Known as “resistance”, this outcome is now one of the most serious challenges in modern medicine and agriculture. Today we face more life-threatening pathogens with fewer antibiotics to use against them.
In 2011 close to 260 million courses of antibiotics were prescribed In the U.S.54 The highest rate went to the youngest among us, with babies receiving about three courses of an antibiotic by the age of 2. By age 10, the estimate ratchets up to about 10 antibiotic courses.55 On average by their late teens, a person in the U.S. is estimated to have had 17 courses of antibiotics, or about one course per year.56 These rates are among the highest in the world. For comparison, the rate in Swedish children is about 60 percent lower.57 A CDC assessment of antibiotic use in pediatric medicine in 2010 estimated that as much as half of all antibiotic prescriptions may be unnecessary.58


It is especially troubling should antibiotics result in the temporary or permanent loss of gut microbiota over the first several years of life. As discussed previously, this is the crucial window of time in which infant immune cells require interactions with a wide diversity and abundance of symbiotic and non-pathogenic microbes to achieve lifelong normal immune function. Indeed, numerous studies on mice and humans document associations between altered gut microbiota composition due to antibiotics early in life and the later onset of a wide range of immune and metabolic disorders. In people this includes asthma, allergies, type 2 diabetes, and obesity. 59
Even if childhood antibiotics are largely avoided, their use in adulthood can also lead to negative health conditions.60 Some gut microbiota swiftly colonize habitats from which symbionts have been eradicated due to antibiotics. The bacterium, Clostridium difficile, is well known to behave this way. Since about 2000, several strains of C. difficile have emerged that produce deadly toxins capable of ravaging a person’s gut tissue and bringing on the fatal condition of sepsis.61 Among hospitalized patients who develop the worst C. difficile infections, more than 90 percent had recently taken antibiotics. The loss of gut symbionts in combination with exposing C. difficile to certain broad-spectrum antibiotics are among the factors thought to have driven the emergence of the highly pathogenic strains. 62
Antibiotics enter our bodies in other ways far beyond the doctor’s office. By the latter decades of the mid-20th century about 80 percent of all antibiotics sold in the U.S. were routinely incorporated into the diet of farm animals like cows, chickens, and pigs. Although mechanisms are not thoroughly understood, antibiotics alter gut microbial communities in ways that accelerate weight gain.63 While the amount of antibiotics that entered the human population via meat and dairy was not monitored, it is interesting to note that overweight and obesity in people increased over roughly the same time period. 64
The decades-long practice of using antibiotics for nonmedical purposes spurred consumer groups and others to take action. Their considerable efforts prevailed only recently. As of June 2023, the Federal Drug Administration requires a prescription from a veterinary doctor to use antibiotics in livestock.65


Mention the word “soil”, and what comes to mind for most people is only the dead part, tiny particles of sand, silt, and clay and the assortment of minerals they contain. But soil is also alive, filled with creatures large and small, legless or multilegged. Some are soft-bodied, others have durable hard outer parts. There are signs of the once-living too, like skeletonized leaves and insect fragments.

However, most of the life in soil—the microorganisms—is outof-sight, well beyond the naked eye. Their numbers are hard to fathom, estimated at about a hundred billion in a teaspoon or so of productive top soil.66 Soils also hold the distinction of being the richest reservoir of microbial diversity on land. This vast abundance and diversity of soil-dwelling microbes is the source for the microbiomes of crops and wild plants alike.
Soil organisms reveal the intimate connections between life and death too. They drive among the most ancient and grand processes on our planet—turning dead plants, animals, and microbes into organic matter to feed themselves. Wriggling earthworms and a menagerie of other invertebrates kick off the transformation of death into new life. They shred, tear, and grind once-living plant and animal parts into ever-smaller pieces. Soil microbes like fungi and bacteria follow up with a variety of enzymes to extract nutrients they need, completing the decomposition process. This massive recycling of life to death and back to life serves a fundamental purpose as well—it keeps elements essential to life in perpetual circulation.
Living plants are another major source of nourishment for soil microbiota, particularly those living on the surface and inside of plant roots as well as the narrow zone of soil around the roots known as the rhizosphere. Crops and all other land plants make “exudates”, a dizzying variety of carbohydrates, fats, and proteins which flow out of their roots into the rhizosphere. In response, soil microbes flock to a plant’s root system, cramming themselves into the rhizosphere at densities up to 100-fold greater than that of the surrounding soil.67
This dynamic—crop hosts using
Exudates, however, are not free. In exchange for this must-have food source, root symbionts acquire nutrients and other compounds from the soil and give them to their crop hosts. It is also common for root symbionts to directly modify compounds in plant exudates, or use the energy derived from exudates to make compounds their crop hosts need. In return, symbionts receive yet more exudates from their crop hosts. The diversity and abundance of exudates underlies why the rhizosphere ranks as one of the most biodiverse and life-dense places on the planet. So long as hosts make and release exudates, crop and soil microbiota will carry out activities crucial to crop survival including:
• acquiring and delivering nutrients in plant-available forms.
• making metabolites needed for plant growth and defense as well as resiliency to environmental stressors like heat or drought.
• contributing organic matter crucial to soil health.
Most significantly, the collective action of microbiome members in the rhizosphere, as well as the soil at large, leads to an outcome of vital importance to humanity— creating and maintaining soil fertility, the foundation of agriculture.










Microflora


A trio of nutrients—nitrogen, phosphorus, and potassium—play an especially important role in the symbioses between crop hosts and root symbionts. Nitrogen is a stand-out among the trio. It is both the most difficult nutrient for plants to obtain, and the one most responsible for fueling the growth of a seedling into a mature plant. Farmers are especially interested in nitrogen because it directly influences crop yields.
Ironically, plants are bathed in nitrogen gas (N2) as it comprises almost 80 percent of the gases in Earth’s atmosphere. However, neither plants (nor animals) can use nitrogen in a gas form.
Fortunately, certain kinds of bacteria—known as “nitrogenfixers”—live in or on roots and freely in the soil. They change nitrogen gas into forms plants can take up, a function similar to gut microbiota modifying components of the human diet to make them host-usable.
The most specialized nitrogen-fixing bacteria live in plant nodules, a stable-like environment inside of plant roots. Safely ensconced and well-fed with exudates, these bacteria carry out the complex and energy-intensive chemistry of converting nitrogen gas into plant-available forms. Noduledwelling bacteria are typically the most dedicated to a host and provide the highest levels of nitrogen. They are well known to associate with legumes, plants in the pea family. For example, nitrogen-fixing bacteria in the roots of field peas can fix between 155 and 175 pounds of nitrogen per acre per year.68 There are also nitrogen-fixing bacteria that live inside of stem and root tissues, but not in nodules. Known as endophytes (“endo” for in, and “phyte” for plant), these type of bacteria were once thought of as insignificant nitrogen-fixers. However, recent research shows that endophytes can provide sufficient levels of nitrogen for rice, wheat, and sugar cane as well as Western red cedar and lodgepole pine.69 Yet other kinds of nitrogen-fixing bacteria live freely in the soil with some found to supply nitrogen to cereal crops. The soil organic matter resulting from microbial decomposition of dead plants and animals is another source of plant-available nitrogen.
Relying on multiple biological sources of nitrogen—nitrogenfixers, soil organic matter, as well as animal manures—to grow crops has been a normative practice for nearly the entire 10,000-year history of agriculture. There was a profound shift in this practice only about a hundred years ago due to the discovery that nitrogen in the air could be turned into soluble nitrogen fertilizers through the industrial Haber-Bosch process. This single event has had lasting influence and created multiple impacts across agriculture. One of the most concerning is the de-coupling of crop hosts from their nitrogen-fixing symbionts.
Mycorrhizal (my-ko-rye-zal) fungi comprise a large group of soil-dwelling fungi. They are quite different from the fungi that decompose dead things and are well known to provide phosphorus, another nutrient in the trio crop hosts require for growth. The namesake of these fungi, “mycorrhizae”, means “fungus root” in Greek. Such fungi embed one end of their body either inside of a root or on the root surface of their crop host(s). Arbuscular mycorrhizal fungi are the former and ectomycorrhizal fungi are the latter. Mycorrhizal fungi exhibit incredible diversity with roughly 50,000 fungal species forming associations with at least 80 percent of all land plants including the world’s three staple crops (wheat, rice, and corn) as well as sweet potato, tomato, potato, soybean, and cassava.71
A number of studies have documented one of the chief benefits of mycorrhizal fungi—the difference they make in plant uptake of nutrients, particularly the trio required for growth, but also others. Research in this area shows increased uptake of phosphorus by 80%, nitrogen by 25%, and potassium by 10% as well as increased uptake of zinc by 5%, and copper by 60% due to mycorrhizal fungi.72,73,74
The phosphorus-provisioning of mycorrhizal fungi has special relevance given the limited amount of high quality rock deposits from which phosphorus is mined. By some estimates, such deposits will have been utilized by 2033.75 However, there is a considerable amount of phosphorus already in soil due to decades of phosphate fertilizer use, which mycorrhizal fungi can access and deliver to crop hosts.


The phosphorus and other nutrients and compounds that mycorrhizal fungi deliver to crop hosts relates directly to a unique aspect of their anatomy. Most of their body is underground and consists of numerous pipe-like filaments called hyphae which coalesce to form a mycelium. Mycelia function much like a vast multi-directional underground transportation and communication network in soil ecosystems. In exchange for exudates, mycelia forage and scavenge extensively in soils for nutrients, trace minerals, and other compounds well beyond the reach of crop host roots. Mycelia also distribute crop host exudates, especially the carbon component, to countless other soil organisms that benefit crops, but live beyond the rhizosphere.
Mycelia play a role in storing soil carbon too. A recent study estimated that plants send an amount of carbon to and through their fungal mycelia that is equivalent to about one third current annual CO2 emissions (13.12 gigatons) on a global basis.76 This finding highlights the important role of mycorrhizal fungi and other soil life in cycling and storing carbon in agricultural soils which is essential for maintaining soil fertility. Further, even dead mycorrhizal fungi confer benefits to their crop hosts. As hyphae die their physical remains provide a trellis-like structure to which soil particles and organic matter adhere. This is crucial for building soil aggregates, which greatly reduces erosion, and thus loss of carbon and other nutrients.


It bears repeating that most life on Earth is microbial, and the vast majority of microbes are not pathogens.
In addition, crops and livestock (and every other form of life) have always lived shoulder to shoulder with pests and pathogens. In fact, crops are far from sitting ducks in routine need of pesticides and other products. Domesticated or wild, land plants thrive in large part because of their stuck-in-place lifestyle. The botanical world’s defense strategy—ceaselessly recruiting and feeding formidable legions of pathogen-deterring microorganisms with exudates—has an enviable 400-million year old track record.
Such symbioses illustrate that normally functioning crop and soil microbiomes can largely prevent ailments and disease from reaching levels high enough to kill or chronically debilitate their crop hosts.
In this regard, crop and soil microbiota are as consequential for crop defense as gut microbiota are for human immunity.
This parallel underscores the vital importance of crop and human hosts providing their respective symbionts with the nutrients to which they are adapted—notably a diverse and steady supply of exudates for root microbiota and fiber and phytochemicals for gut microbiota. In many respects, the interactions between crop hosts and root and soil symbionts, particularly those related to host defense and immunity, parallel those between gut symbionts and human hosts. Specific functions of root and soil symbionts include:
1.
Maintaining dense populations in the rhizosphere and soil at large to deprive pathogens of habitat and nutrients.
2. 3. 4. 5.
Activating host plant immune responses.
Parasitizing pathogens.
*Soil

Producing a wide range of compounds to suppress pathogens.
Acquiring nutrients and producing compounds needed to counter disease and infections and normalize metabolism of crop hosts.
The above activities dynamically transition from one to another depending on context including, for example, the type and density of pathogens, cropping practices, and background soil nutrient levels. Many root symbionts make metabolites that induce crops to make one or more of the three plant hormones governing plant immunity in response to pathogens and other stressors. These hormones go on to activate gene pathways vital to plant defense. For example, plants can make tissue modifications such as thickening cell walls where a pest or pathogen first gained entry to prevent future access at the same location. Other times root symbiont-driven hormone production leads to crops pre-preparing toxins (or their precursors). Quick responsiveness such as this is key to halting levels of pathogen colonization and subsequent population growth that lead to debilitating levels of disease or early death in crops. Root symbionts are also instrumental in spurring crops to make compounds needed to withstand harsh conditions like drought.
One well-known case of root symbionts inducing defensive responses in hosts involves Pseudomonas bacteria. They produce DAPG a compound well known to suppress bacterial, viral, fungal, protist, and nematode plant pathogens in both agricultural and wildland settings. The Pseudomonas DAPG-producers have been extensively studied in the context of “take-all”, a serious fungal pathogen of wheat. When heavily infected, wheat plants modify their exudate composition—to a mix that attracts the Pseudomonas DAPG-producers. As their populations grow, DAPG levels rise in the vicinity of roots and suppress the take-all pathogen to nondisease levels.
Many different species of bacterial and fungal root symbionts also stimulate crops to make phytochemicals. These compounds, which number in the tens of thousands, are another major part of a crop’s defensive repertoire. They help crops deter pests and pathogens and also contribute significantly to crop resiliency in the face of harsh physical conditions, such as freeze, drought, and heat.


Many of the phytochemicals protective for crops also confer benefits to people, but here again, it requires help from microbial symbionts.
For example, certain colonic-dwelling gut microbiota are known to modify polyphenols, one of the largest groups of phytochemicals found in the human diet. Such microbial modifications underlie the protective effects of many phytochemicals on human health including anti-oxidant activities that maintain cellular integrity and modulation of healthy human immune responses.77 In general, phytochemical levels in foods of the human diet are highest in crops (and livestock) where the soil and crop microbiomes are least disturbed.78,79

Communities of microbes rather than any one species are key for crop hosts to effectively push back on pests and pathogens. Research on the fungal root pathogen, Rhizoctonia solani (which impacts wheat, potato, rice, and sugar beet crops) found that eleven strains of rhizosphere-dwelling bacteria in the Streptomyces genus were among the top 10 percent of taxa linked to suppressing the pathogen. The eleven strainStreptomyces consortia produced compounds inhibiting the growth of R. solani fungal hyphae and simultaneously promoted crop shoot and root growth.80 Similar results from using multi-strain bacterial symbionts were also found effective in countering another fungal root pathogen, Ralstonia solanacearum, which causes plants to suddenly wilt and die. Other research using controlled experiments has also shown that as the soil microbial community becomes more diverse, pathogen populations in the soil decline, greatly lessening the infection of roots.81
While fungal pathogens present serious challenges, there are other groups of fungi in agricultural settings with formidable pathogen-control capabilities. One of the most studied is Trichoderma. Species of this fungus live in the rhizosphere, in or on plant tissues, and freely in soil where they carry out an extraordinary range of activities that control pathogens and promote crop growth. Trichoderma are well known for parasitizing their pathogenic fungal cousins. Many also produce anti-fungal compounds, spur plant immune responses, and control non-microbial pathogens (e.g., root-eating nematodes).
Research on wheat, beans, and several vegetables and fruits shows that pairing different Trichoderma with well-known bacterial root symbionts (Bacillus and Pseudomonas) reduces or inhibits many top agricultural pathogens. These effects were attributed to high population levels of Trichoderma-bacteria combinations and their respective fungal and bacterial enzymes, as well as other symbiont-made compounds (e.g., hydrogen cyanide) that disabled or harmed the pathogens.82


A fundamental tension has always accompanied the numerous benefits humanity reaps from agriculture. Some of the most basic practices, like tilling soil to plant seeds, inherently disturb crop and soil microbiota. Another major source of impacts is chemical disruption, which stems from relying on nitrogen fertilizer and pesticides to grow crops.
These combined impacts created a vexing challenge for farmers and humanity at a global scale. Over millennia, the physical disruption of tillage led to a steady reduction in the productive capacity of agricultural soils. So what is the fix? That depends. Are we facing a problem of degraded soils, or the issue of crop yields? The truth is, these two are intimately connected. By the mid-20th century, a course of action was firmly in place for how to squeeze yields out of the tillage-degraded soils covering America’s major farmland regions. Farmers could purchase fertilizers and an array of pesticides and other new products to compensate for tillage-damaged soils and declining crop and soil microbiota populations. Other changes paralleled and complemented these, notably larger farms and greater industrialization of farm operations. Eight decades later, it’s time to take stock and ask—how are things working?

A plow running through the soil is among the most iconic farming practices, dating back to the earliest days of agriculture. But over millennia, and despite the vast changes in tools and implements, tillage has led to substantial soil erosion across agricultural landscapes and led to the demise of civilizations throughout human history . Many conditions influence tillage-related soil erosion, among them slope and underlying soil type as well as the type of plow. Layered onto these is the factor of time. A single pass of a plow typically causes negligible erosion, but routine plowing over decades and centuries in the same place frequently exceeds background erosion rates due to wind and water. For example, recent research documented that the native topsoil is gone from about one third of the Corn Belt region due to plow-induced erosion over the last 150 years.84 The affected area covers nearly 30 million acres. In addition, there was also a six percent decline in crop yields, despite routine nitrogen fertilizer applications.
Tillage-induced erosion leads to other impacts for crop and soil microbiota. Of primary concern is the loss of soil organic matter—for carried away in eroded soil is the organic matter crop symbionts and other forms of soil life need to thrive. Cumulative loss and little to no replenishment of organic matter for soil parallels the fiber deprivation of human gut microbiota due to the modern human diet.
In addition, life forms as small and delicate as single-celled bacteria and the trillions of fungal hyphae that compose mycelia are particularly vulnerable to tillage. Many are inevitably injured or killed. Deep, soil-inverting tillage methods generally cause the most harm. Declines in beneficial fungal populations, for example, can lead to other losses. Soil fungi build and maintain soil aggregates85 a physical feature needed for optimal organic matter storage and water-holding capacity.86 Plowing itself, well known to break up soil aggregates, only worsens these problems.
Some practices used in combination with tillage can offset impacts on crop and soil microbiota.87 Among them are adding organic matter in the form of compost and manure and keeping soil covered with mulch to prevent erosion. Routine use of cover crops and devising complex crop rotations are another method to ensure adequate levels of organic matter for crop and soil microbiota. They can also be a strategy to keep soils covered and prevent erosion. Other ways to minimize soil disruption include reducing the use of deep, soil-inverting tillage equipment, simply plowing less, and using low-disruption weed control methods such as tine weeders.
As such practices begin normalizing the functions of soils and crop and soil microbiota, it creates conditions that allow farmers to transition away from synthetic fertilizer and pesticides, which in turn greatly reduces chemical disruption of these products not only on crop and soil microbiomes, but all soil life.


The routine use of synthetic fertilizers, especially nitrogen and phosphorus, are problematic for crop and soil microbiota. They inevitably disrupt the exudates-for-nutrients exchanges that initiate and sustain the symbioses that keep crop hosts and microbiomes linked to each other. For example in a study investigating nitrogen fertilizer use over a period of nearly 40 years in eastern China researchers found that as fertilizer levels increased, bacterial symbionts cut back— by 50 percent—the amount of nitrogen provided to crop hosts. 88 The reason? When crops get nitrogen from fertilizers, they cut back on feeding exudates to the symbionts they previously relied on for nitrogen deliveries. The biggest decreases were among species of nitrogen-fixing bacteria known for providing the highest levels of nitrogen to crop hosts. The least impacted species were not only less adept at provisioning nitrogen, but also most able to shift to non-exudate nutrient sources (i.e., to a less symbiotic relationship). A reduction in the overall diversity of nitrogen-fixing bacteria was another outcome of long-term fertilization documented in the study.
Another effect of fertilizers, and in particular nitrogen, is the growth-inducing effect it has on types of bacteria and other microbes that decompose soil organic matter.89 Increases in their populations speed up organic matter decomposition, often releasing nutrients non-synchronous with crop growth.
Research on the effects of phosphorus fertilizers on mycorrhizal fungi, the main phosphorus-provisioning symbiont, reveal much the same story as with nitrogen fertilizers.90 Specific mechanisms by which phosphorus fertilizers degrade crop symbioses with mycorrhizal fungi depend on factors such as crop type and fungal species. For example, in some cases a reduction in crop exudates leads to underdeveloped arbuscles, the part of the mycorrhizal fungal body living inside of root cells across which phosphorus and exudates are exchanged.
Crop hosts lose not only nutrient deliveries from their symbionts due to high fertilizer use, but also other benefits, many related to crop health and defense. Declining or low populations of symbionts in, on, and around roots leaves these areas open to pathogen colonization. In addition, loss of symbionts can also deprive crop hosts of the crosstalk integral to spurring robust immune responses and tolerating harsh physical conditions.
Pesticides are another contributor to the deterioration of beneficial interactions between crop hosts and symbionts. Fungicides are extremely problematic. Although intended for pathogenic fungi, they also harm many species of mycorrhizal fungi through inhibiting hyphal growth and spore germination needed to build and maintain an extensive mycelial network. As a consequence, symbiont deliveries of phosphorus and other nutrients and beneficial compounds to crop hosts can decline substantially. Many fungicides are also toxic to nitrogen-fixing bacteria and thus reduce nitrogen provisioning to crop hosts. Impacts on nitrogenfixing bacteria can compound when both herbicides and fungicides are used. In one case the nitrogen-fixing bacterium, Sinorhizobium meliloti reduced nitrogen deliveries by almost 90 percent.91

It is an irony of industrial agriculture that by providing nitrogen in the forms most easily taken up by living things, much of it is squandered. On a global basis, for instance, only one-third of applied its way into the proteins and other nitrogen-bearing compounds in cereal
Much of the rest escapes into the air or water. Fertilizer goes airborne in the form of volatile ammonia (NH3), or when converted by certain bacteria in waterlogged soils to nitrous oxide (N2O) or dinitrogen gas (N2), the former a global warming gas 300 times more potent than carbon dioxide. This bacterially-mediated denitrification, can convert 5 to 20 percent of nitrogen fertilizer to N2 or N2O.93
known as nitrification, bacteria transform fertilizer into water-soluble nitrate
). While nitrate is easily assimilated by plants and microbes, it is also highly mobile in soil and readily leaches into groundwater. In fact, 10 to 20 percent of nitrogen fertilizer is lost as nitrate
Excessive nitrate levels in well-water, often found in rural areas with intensive fertilizer use, are associated with methemoglobinemia (blood disorder impairing delivery of oxygen to tissues) and preterm birth.95
In another process known as nitrification, bacteria transform fertilizer into water-soluble nitrate (NO3-). While nitrate is easily assimilated by plants and microbes, it is also highly mobile
Still more fertilizer is lost in runoff, much of it bound to sediment.96 This nitrogen-rich runoff ends up in the world’s bays, where it supercharges the growth of algae, which die and sink to the ocean floor. There, microbes decompose the dead algae, which depletes oxygen in the water and kills bottom-dwelling life, which in turn leads to huge “dead zones” for months every year The Gulf of Mexico and the Chesapeake Bay are among 400 such dead zones around the world.97
Why so much waste? Because huge pulses of nitrogen fertilizer overwhelm the capacities of plants and their microbial partners to utilize it. In fact, only 10% to 50% of applied nitrogen is retained by soil microbes (i.e. immobilized) within the first year after fertilization.98
To make matters worse, nitrogen overload accelerates microbial decomposition of organic matter, which over years leads to soils depleted of both soil organic carbon


The negative effects of high nitrogen fertilizer use also roost in crops themselves. When nitrogen is supplied at high levels, the portion crops take up is typically not assimilated into new tissues all at one time. What is not used immediately gets stored as amino acids in roots and leaves. However, amino acids are a highly preferred food for pests and pathogens. As a consequence, crops grown in high nitrogen fertilizer settings have been found to attract pests and pathogens. For example, in food choice experiments aphids, leafhoppers, and other phloem-feeding insects exhibited clear preferences for plants grown under the highest nitrogen fertilizer applications.100 Such increased pest pressure creates dire circumstances for crops. Just when crop hosts most need their symbionts for defense, they are least available, due in large part to the initial effect of fertilizers—starving symbionts of exudates.
The use of crops genetically modified to tolerate herbicides is another pathway by which root symbionts experience chemical disruption. For example, research on glyphosate-tolerant crops reveals they can incorporate glyphosate into their exudates, leading to subsequent reductions in root symbionts, as occurred with fluorescent Pseudomonas species.101 As these particular bacteria are known to deliver manganese to crop hosts, produce plant defense compounds, and compete with the fungal root pathogen Fusarium, a reduction in their numbers likely has negative effects on crop health.
Glyphosate in combination with other herbicides illustrates yet another way herbicides can impact crop and soil microbiota. Growing glyphosate-resistant canola in soils receiving pre-plant soil applications of glyphosate and the herbicide 2,4-D led to larger reductions in bacterial diversity relative to soils treated with either herbicide alone. In addition, only a few functional groups of bacteria dominated after herbicide applications, laying the groundwork for diminished soil food webs and impaired biological processes.102
Some studies demonstrate that glyphosate is toxic to nitrogen-fixing rhizobia bacteria living in the roots of glyphosate-resistant soybeans. As a consequence, nitrogen fixation was reduced as well as crop biomass and seed yield, particularly under dry conditions.103,104 Other research suggests that glyphosate’s suppression of root symbionts leads to nutritional deficits in glyphosate-resistant crops. 105 Compounding this impact is another of glyphosate’s properties—binding soil minerals, many of which are foundational to plant immunity (i.e., iron).106 Even crops planted in fields previously treated with glyphosate are more likely to suffer fungal diseases such as Fusarium head blight, as was demonstrated with wheat and barley in Canada.107
Not all studies on glyphosate-resistant crops report consistent findings regarding impacts on root symbionts. On this point, it is generally acknowledged that the variability of soil health, crop microbiota, other farming practices, and local environmental conditions complicate definitive conclusions. While some might interpret such complexity as inconsequential, it is more likely that we have an incomplete understanding of the pathways by which herbicide-tolerant crops impact crop and soil microbiomes. One area in particular concerns the well-known general response of bacteria subjected to stressors.



Herbicides, though developed to use on plants, have been found to influence bacteria as well. The co-exposure of two different bacteria (Escherichia coli and Salmonella enterica serovar Typhimurium) to glyphosate, 2,4-D, or dicamba and several types of medically important antibiotics altered how the bacteria responded to the antibiotics. In some cases their susceptibility to the tested antibiotics decreased, in others it increased. 108
Another study revealed that exposure of soil bacteria solely to glyphosate, glufosinate, or dicamba in various soil types increased the abundance of genes with known resistance to antibiotics.109 Other types of genes increased too, those that help resistance genes move among different bacteria. The widespread occurrence of herbicides not only in soil, but also air, water, and food, 110 raises troubling implications about these research findings. Bacteria in these same environments, including human pathogens, are potentially subjected to the stressor effects of herbicides as well. This outcome, in turn could contribute to more antibiotic-resistance in human medicine.
The incompletely understood effects of herbicide use exemplifies a nearly century-old pattern in modern agriculture.
Many products and associated practices attempting to solve one problem, frequently worsen an existing problem, or generate a different problem, often as serious as the original problem. Then another product is created, and the cycle continues.
Thus far, this dynamic has failed to address the fundamental problem that has long plagued many American farms and farmers—the impairment of crop and soil microbiome due to chronic soil degradation. This outcome suggests we are overdue for making changes in American agriculture.

Scientific revolutions are rare, but when they do happen they upend long-held ideas and views about the world and our place in it. Microbiomes are now in that league alongside evolution and plate tectonics. The microbiome revolution comes with a twist—it has near-term direct application to our well-being and that of our planet. Indeed, human choices will determine whether microbiomes continue to deteriorate and suffer chronic disturbance or, whether they regain normal function.
One now commonly acknowledged aspect of the microbial world is its immense diversity and the adaptability it confers. This hallmark is both confounding and prescient. On the one hand it allows pathogens to thwart one product after another in agriculture and human medicine. But on the other hand, such adaptability also offers a well of solutions for major problems plaguing agriculture and human health.
Ultimately, the future practices and products used in agriculture and medicine will look and work quite differently from those we consider mainstream today. So, how do we get there? Perhaps the most crucial thing in this regard is changing how we think—about microbiomes specifically, and the microbial world in general. Simply put, we’ll need a mindset and overarching, explicit focus on cultivating and nourishing the beneficial microbiota indigenous to human and agricultural microbiomes.
Paramount to this effort is re-tooling practices and products so they enable microbiomes to develop and maintain symbioses with their hosts. It will also be essential to protect the habitats and natural processes in which beneficial microbiota are nested. For as laid out in this white paper, an abundance of evidence shows that when gut and soil habitats remain intact, normal microbiome functions generally follow suit—from suppressing pathogens to producing metabolites vital to normal host biology.
Will this approach succeed? We can’t know unless we embark on the journey. But one thing is certain. There is ample evidence that microbiomes do not—and cannot—function normally for hosts when habitats in the gut, the rhizosphere, and soil at large experience constant chemical and physical disturbance.
Restoring function to the human microbiome and those we need in agriculture will prove a large and complex undertaking at every societal level across America. Despite the profound effects of personal decisions on microbiomes linked to farming practices, birthing a child, or what to eat, other forces set the boundaries on the range of choices available to farmers, mom’s-to-be, and one’s daily food choices. The goals and motivations of corporations, governments, and other organizations as well as a person’s family and community environment, and socioeconomic status are among these larger forces.
But, a basic framework—one centered on how microbiomes work and what microbiomes need to work—offers a way to start the proverbial ball rolling.
It can act as a compass to stimulate discussion and set the direction for later phases of microbiome recovery, such as policy development and identifying suitable criteria for new practices and products. In addition, continuing agricultural and human microbiome research is another fundamental aspect of their recovery. In particular is research focused on the aspects of symbioses that help ensure normal function of agricultural and human microbiomes. Use of a framework continuously informed by up-to-date knowledge and evidence about microbiomes also offers a way to facilitate and leverage actions across different societal sectors. Figure 1 illustrates what a basic framework might look like, and outlined below are brief descriptions of the chief themes under each framework component.
Framework Component 1:
Acknowledge How Human and Agricultural Microbiomes Function

Framework Component 2:
Provide the Conditions Needed for Human and Agricultural Microbiomes to Function Normally
The symbiotic relationships on which human, crop, and animal hosts and their microbiomes rely is crucial to their collective functioning and welfare.
Accommodating and supporting host symbionts is particularly important in the following areas:
• Diets and environments are well-suited to the major life stages and changing physiological needs of hosts.
• Symbionts receive sufficient access to nutrients and compounds from host-associated diets, metabolites, and environments.
• As a natural consequence of hosts interacting with their symbionts, human immunity and metabolism, crop growth and defense, and soil nutrient cycling are maintained.

Framework Component 3: Modify Practices and Products to Support Microbiomes and Their Hosts
The following conditions are essential for recovering symbioses between microbiomes and their hosts:
• Habitats in which host microbiota can live and maintain their populations, including access to nutrients to which they are adapted and ability to fulfill functional roles related to sustaining natural processes.
• Low degree and short duration physical and chemical disturbance to microbiota food sources and habitats.
• Ability to carry on community-level interactions with host cells and other microbiota fundamental to maintaining symbioses with hosts.

From a triage perspective, injury to microbiomes is already at a sufficiently high level to warrant immediate intervention.
For the human microbiome, the highest priority areas for intervention are:
• Host diet and exposure to environmental toxins across the lifespan.
• Host antibiotic usage.
• Birth mode of infants.
For soil and crop microbiomes, the highest priority areas for intervention are:
• Tillage levels.
• Fertilizer and pesticide usage.
• Genetically modified crops and their associated microbiome-

Transitioning from acknowledgement and acceptance of how microbiomes work to practices and products that are both safe and supportive for them would occur over two different time scales. Short-term interventions would be deployed initially. Their aim is to alleviate acute symptoms and injury and set the stage for lasting recovery. A potential shortterm intervention is inoculating gut or soil habitats with indigenous microbiota, supported by respective shifts in diet and farming practices that allow transplanted symbionts to re-establish their populations.
Once short-term interventions have successfully begun the process of normalizing microbiome functions, long-term actions would take their place. They have a fundamentally different purpose— to sustain the re-established natural processes and interactions linking hosts and microbiomes to one another. In other words, the symbioses that imbue human and agricultural microbiomes with high functionality are maintained as a consequence of future products and practices. This aspect of recovery is akin to healing processes that re-grow the connections needed to re-establish functions. An example for the human microbiome is how vaginal birth ensures the transmission of maternal microbiota needed for normal immunity to future generations. Another, from agriculture, is the way providing crop exudates and organic matter helps to maintain populations of beneficial soil microbiota from which crops recruit their microbiome.

Whether a future practice or product, those most likely to sustain restored microbiome functions share a fundamental mode of action. As a consequence of their use, they safeguard and conserve the integrity of microbiome-host symbioses. In this context, future practices and products—and the programs and policies supporting them—would have the following features:
• In most cases, changes in practices take the lead with new products playing a supporting role.
• Practices are highly tailored and iterative, rather than prescriptive given the dynamic and unique nature of microbiomes and their high and rapid responsiveness to changes in host and environmental factors.
• The evaluation of new practices and products should focus on the desired outcomes of microbiome recovery, such as human immune system function and disease suppressive soils, as well as the natural processes and related ecological and biological factors on which these functions depend.
Putting mutually beneficial relationships—symbioses— at the center of recovering microbiome functions is a sound strategy for human health and modern agriculture. Partnerships between radically different life forms are one of the longest running phenomena we know about in the history of life, fashioned and honed on the durable anvil of deep time, and successfully tested across Earth’s past and present ecosystems over millions of years. Time and again such relationships have enabled innumerable life forms, including humans to flourish and persist. This fundamental pattern of life suggests how we ourselves might best proceed— in symbioses with our own microbiome and those we need for the future of agriculture.

Acknowledge how human & agriculture microbiomes function
Provide the conditions needed for human and agricultural microbiomes to function normally
Modify practices and products to support microbiomes and their hosts
Practices and products specific to the AGRICULTURE REALM (for soils, crops, & livestock)
Practices and products specific to the HUMAN REALM (for people)
Amino acid: Nitrogen-containing molecules used to build larger proteins. One or more of approximately twenty amino acids comprise proteins found in humans and plants.
Antibiotic: Naturally produced and synthetic compounds with antimicrobial effects. Frequently used to counter bacterial pathogens in people and animals.
Archaea: Single-celled organisms similar to but structurally distinct from bacteria.
Autoimmunity: A disorder of the immune system in which inflammation and related aspects damage or destroy healthy cells and tissues. Type 1 diabetes and rheumatoid arthritis are autoimmune diseases.
Biocide: Herbicides, fungicides, insecticides, and other products made for specific types of agricultural pests and pathogens. Many also harm non-pest organisms.
Biodiversity: The number and type of species in an area or habitat. Alpha diversity refers to diversity within a single locale or site, while beta diversity compares two or more locations.
Chimeric: Organisms made of cells with more than one distinct genotype.
Chronic Disease: Health conditions that last 1 year or more and require ongoing medical attention or limit activities of daily living or both.
Crosstalk: The use of different metabolites or other compounds by microbiomes and hosts to communicate with one another.
Cytokine: Proteins made and used by immune and other cells to communicate with one another; generally categorized as having pro- or anti- inflammatory effects.
Enzyme(s): Chemical compounds plants, animals, and microbes make that catalyze biochemical reactions such as organic matter decomposition in soil, or digestion in the human gut. Enzymes end in “ase”, like lactase, the enzyme that breaks down lactose.
Exudates: Plant-made compounds crops and other plants release from their roots to attract microbes. Primary components include amino acids, sugars, fats, and phytochemicals.
Fiber: A general term for the parts of plant foods that people cannot digest. Fiber consists of mostly complex carbohydrates, but also non-carbohydrates (e.g., lignin).
Genetically engineered/modified seeds: Plants, animals, and other organisms whose genomes have been modified through laboratory-based technologies. Alterations typically consist of changing a single base pair, deleting a region of DNA, or adding a new segment of DNA.
Genome: The sum total of an organism’s genetic material, whether microbe, person, or plant.
Germ-free mice: Mice raised to have no microbes living on or within them.
Gut-Brain Axis: Continuous bidirectional communication between the gut and the brain involving nerve, endocrine, and other cells in the gut. Much of this communication regulates immunity, digestion, satiety, and stress among other things.
Host: An organism that is the home of another organism. Typically, the host is the larger of two organisms. The smaller organism can be commensal, wholly beneficial, or a parasite.
Hyphae: The part of fungi that grow extensively throughout the soil as single filaments and collectively known as a mycelium (singular) or mycelia (plural).
Inflammation: A fundamental aspect of human immunity to protect and repair cellular damage due to infection, injury, or other factors. Inflammation coordinates immune cell activity and the release of chemicals to initiate or resolve an immune response. Inflammation may be either acute or chronic; helpful or harmful.
Macrophage: One of the largest types of immune cells. Macrophages ingest pathogens and cellular debris as part of the human immune response.
Metabolite: Molecules or compounds that are by-products of an organism’s metabolism. Many microbial metabolites are critical for normal growth, development, and immunity of hosts.
Metagenomics: the study of the structure and function of entire nucleotide sequences isolated and analyzed from all the organisms (typically microbes) in a single sample.
Microbiome: The sum total of all microorganisms and their genetic material in a host or habitat.
Microbiota: The collective microbial inhabitants of parts of a host or ecosystem.
Microbe: Colloquial term for “microorganism.”
Microorganism: Life forms generally too small to see with the naked eye. Most are single-celled (e.g. bacteria) though some are multi-cellular (certain algae).
Microglia: A type of immune cell in the brain and spinal cord.
Micronutrients: In nutrition, the minerals (e.g., zinc) and vitamins in foods needed in relatively small quantities and critical to health in animals and plants. Micronutrients facilitate the action of enzymes.
Mycorrhizal fungi: Specialized fungi that form symbiotic relationships with plants through establishing physical connections with plant roots.
Nitrogen-fixing: The chemical process by which certain specialized soil microbes convert the gaseous form of nitrogen into plant-available forms.
Organic matter: Compounds derived from life forms found in soil and crucial to soil fertility.
Photosynthesis: The process through which plants convert carbon dioxide and water into complex carbohydrates (sugars). Photosynthesis occurs in chloroplasts, organelles descended from once free-living bacteria.
Phylum A taxonomic rank above class and below kingdom. In botanical taxonomy phylum and “division” are the same. Phytochemical: Compounds produced by plants that have a wide range of functions related to defense and health, including communication with microbes.
Rhizobia: Bacteria that live in nodules on plants roots and convert or “fix” atmospheric nitrogen into plant-available chemical forms. Some are in the genus, Rhizobium.
Rhizosphere: The narrow zone of soil surrounding plant roots heavily influenced by plant exudates and associated microbiota.
(SCFAs): A subset of fatty acids colonic microbiota produce through fermenting complex carbohydrates in the host diet that benefit human health.
Soil Biota: All the different life forms for which soil is their natural habitat.
Symbiont: An organism that establishes a long-term relationship with its host.
Symbiosis: A close physical and mutually beneficial relationship between two or more organisms belonging to different species.
Taxa / Taxon: A group of any rank, e.g. from species to phylum in the standard Linnaean classification system. Taxa is plural and taxon is singular.
Hug, L., et al. 2016. A new view of the tree of life. Nature Microbiology, vol. 1, article no. 16048. https://doi. org/10.1038/nmicrobiol.2016.48
Rappuoli, R., et al. 2023. Save the microbes to save the planet. A call to action of the International Union of the Microbiological Societies (IUMS). One Health Outlook, vol. 5, article no. 5. https://doi.org/10.1186/s42522-02300077-2
Luczynski, P., et al. 2016. Growing up in a bubble: Using germ-free animals to assess the influence of the gut microbiota on brain and behavior, International Journal of Neuropsychopharmacology, vol. 19, pp. 1-17. https:// doi.org/10.1093/ijnp/pyw020
Schlatter, D., et al. 2017. Disease suppressive soils: new insights from the soil microbiome. Phytopathology, vol. 107, pp. 1284-97. doi.org/10.1094/PHYTO-03-17-0111-RVW
Matos, A., Kerkhof, L., and Garland, J.L. 2005. Effects of microbial community diversity on the survival of Pseudomonas aeruginosa in the wheat rhizosphere. Microbial Ecology, vol. 49: pp. 257-264 and van Elsas, J.D. et al. 2012. Microbial diversity determines the invasion of soil by a bacterial pathogen. Proceedings of the National Academy of Sciences, vol. 109, pp. 1159-64.
Krautkramer, K. A., Fan, J., and Bäckhed, F. 2021. Gut microbial metabolites as multi-kingdom intermediates. Nature Reviews Microbiology, vol. 19, pp. 77–94. https://doi.org/10.1038/s41579-020-0438-4
Gilbert, J., et al. 2018. Current understanding of the human microbiome. Nature Medicine, vol.24, pp. 392–400. https://doi.org/10.1038/nm.4517
Tierney, B.T., et al. 2019. The landscape of genetic content in the gut and oral human microbiome. Cell Host Microbe, vol. 14, pp. 283-295. doi: 10.1016/j.chom.2019.07.008.
Montgomery, D. and Biklé, A. 2016. The Hidden Half of Nature: The Microbial Roots of Life and Health. W.W. Norton Company, New York, NY, 309 pp.
McFall-Ngai, M., et al. 2013. Animals in a bacterial world, a new imperative for the life sciences. Proceedings of the National Academy of Sciences, vol. 110, pp. 3229–3236. doi.org/10.1073/pnas.1218525110
Needham, B.D., Kaddurah-Daouk, R., and Mazmanian, S.K. 2020. Gut microbial molecules in behavioural and neurodegenerative conditions. Nature Reviews Neuroscience, vol. 21, pp. 717–731. https://doi.org/10.1038/ s41583-020-00381-0
Dominguez-Bello, M.G., et al. 2010. Delivery mode shapes the acquisition and structure of the initial microbiota across multiple body habitats in newborns. Proceedings of the National Academy of Sciences, vol. 107, pp. 11971-11975. doi: 10.1073/pnas.1002601107.
Brodin P. 2022. Immune-microbe interactions early in life: A determinant of health and disease long term. Science, vol. 376, pp. 945–950. https://doi.org/10.1126/science.abk2189
Kalliomaki, M., et al. 2008. Early differences in fecal microbiota composition in children may predict overweight. American Journal of Clinical Nutrition, vol. 87, pp.534–538. https://doi.org/10.1093/ajcn/87.3.534
Dominguez-Bello, M.G., et al. 2019. Role of the microbiome in human development. Gut, vol. 68, pp.1108-1114. https://gut.bmj.com/content/68/6/1108
Cheng, Y.-J. and Yeung, C.-Y. 2021. Recent advance in infant nutrition: Human milk oligosaccharides, Pediatrics & Neonatology, vol. 62, pp. 347-353. https://doi.org/10.1016/j.pedneo.2020.12.013.
Hinde, K. and Lewis, Z.T. 2015. Mother’s littlest helpers. Science, vol. 348, pp.1427-8. doi: 10.1126/science. aac7436.
Hinde, K. and Lewis, Z.T. 2015. Mother’s littlest helpers. Science, vol. 348, pp.1427-8. doi: 10.1126/science. aac7436.
Fusco, W., et al. 2023. Short-chain fatty-acid-producing bacteria: Key components of the human gut microbiota. Nutrients, vol.15, article no. 2211. doi: 10.3390/nu15092211.
Fusco, W., et al. 2023. Short-chain fatty-acid-producing bacteria: Key components of the human gut microbiota. Nutrients, vol.15, article no. 2211. doi: 10.3390/nu15092211.
Mann, E.R., Lam, Y.K., and Uhlig, H.H. 2024. Short-chain fatty acids: linking diet, the microbiome and immunity. Nature Reviews Immunology, vol. 24, pp. 577-595. https://doi.org/10.1038/s41577-024-01014-8
Recharla, N., Geesala, R., and Shi, X.-Z. 2023. Gut microbial metabolite butyrate and its therapeutic role in inflammatory bowel disease: A literature review. Nutrients, vol. 15, article no. 2275. https://doi.org/10.3390/nu15102275
Martin, A. M., et al. 2019. The influence of the gut microbiome on host metabolism through the regulation of gut hormone release. Frontiers in Physiology, vol. 10, article no. 428. https://doi.org/10.3389/fphys.2019.00428
Aho, V.T.E., et al. 2021. Relationships of gut microbiota, short-chain fatty acids, inflammation, and the gut barrier in Parkinson’s disease. Molecular Neurodegeneration, vol. 16, article no. 6. https://doi.org/10.1186/s13024-02100427-6
Needham, B.D., Kaddurah-Daouk, R., and Mazmanian, S.K. 2020. Gut microbial molecules in behavioural and neurodegenerative conditions. Nature Reviews Neuroscience, vol. 21, pp. 717–731. https://doi.org/10.1038/s41583020-00381-0
Lange, O., Proczko-Stepaniak, M., and Mika, A. 2023. Short-chain fatty acids—a product of the microbiome and its participation in two-way communication on the microbiome-host mammal Line. Current Obesity Reports, vol. 12, pp. 108–126. https://doi.org/10.1007/s13679-023-00503-6 and van de Wouw, M., et al. 2018. Short-chain fatty acids: microbial metabolites that alleviate stress-induced brain-gut axis alterations. The Journal of Physiology, vol. 596, pp. 4923-4944. doi:10.1113/JP276431
Furman, D., et al. 2019. Chronic inflammation in the etiology of disease across the life span. Nature Medicine, vol. 25, pp. 1822-1832. https://www.nature.com/articles/s41591-019-0675-0
Morais, L. H., Schreiber, H. L., 4th, and Mazmanian, S. K. 2021. The gut microbiota-brain axis in behaviour and brain disorders. Nature Reviews. Microbiology, vol., 19, pp. 241–255. https://doi.org/10.1038/s41579-020-00460-0
Yu, L. W., Agirman, G., and Hsiao, E. Y. 2022. The gut microbiome as a regulator of the neuroimmune landscape. Annual Review of Immunology, vol. 40, pp. 143–167. https://doi.org/10.1146/annurev-immunol-101320-014237
Nunzi, E., et al. 2024. Host-microbe serotonin metabolism. Trends in Endocrinology and Metabolism: Advance online publication. https://doi.org/10.1016/j.tem.2024.07.014 and Sharon, G., et al. 2014. Specialized metabolites from the microbiome in health and disease. Cell Metabolism, vol. 20, pp. 719-730. https://doi.org/10.1016/j. cmet.2014.10.016.
Needham, B.D., Kaddurah-Daouk, R., and Mazmanian, S.K. 2020. Gut microbial molecules in behavioural and neurodegenerative conditions. Nature Reviews Neuroscience, vol. 21, pp. 717–731. https://doi.org/10.1038/s41583-02000381-0
Mayer, E. A., 2016. The Mind-Gut Connection : How the Hidden Conversation Within Our Bodies Impacts Our Mood, Our Choices, and Our Overall Health. Harper Wave, New York, NY 309 pages.
Bastian, B. et al. 2020. Mortality trends in the United States, 1900–2018. National Center for Health Statistics. https://www.cdc.gov/nchs/data-visualization/mortality-trends/index.htm
Centers for Disease Prevention and Control. Accessed November, 2024. https://www.cdcfoundation.org/safeguarding-americans-health#:~:text=Why%20it%20matters,our%20nation’s%20health%20care%20costs
Furman, D., et al. 2019. Chronic inflammation in the etiology of disease across the life span. Nature Medicine, vol. 25, pp. 1822-1832. https://www.nature.com/articles/s41591-019-0675-0
Sonnenburg, E. D. and Sonnenburg, J. L. 2014. Starving our microbial self: the deleterious consequences of a diet deficient in microbiota-accessible carbohydrates. Cell Metabolism, vol., 20, pp. 779–786. https://doi.org/10.1016/j. cmet.2014.07.003
https://www.ers.usda.gov/data-products/chart-gallery/gallery/chart-detail/?chartId=83141 Accessed October 2024
Gross, L. S., et al. 2004. Increased consumption of refined carbohydrates and the epidemic of type 2 diabetes in the United States: an ecologic assessment. The American Journal of Clinical Nutrition, vol. 79, pp. 774–779. https://doi.org/10.1093/ajcn/79.5.774
Baraldi L.G., et al. 2018. Consumption of ultra-processed foods and associated sociodemographic factors in the USA between 2007 and 2012: evidence from a nationally representative cross-sectional study. British Medical Journal Open, vol. 8, article no. e020574. doi: 10.1136/bmjopen-2017-020574.
Schnorr, S., et al. 2014. Gut microbiome of the Hadza hunter-gatherers. Nature Communications, vol. 5, article no. 3654. https://doi.org/10.1038/ncomms4654 and Clemente, J. C., et al. 2015. The microbiome of uncontacted Amerindians. Science Advances, article no. e1500183. https://doi.org/10.1126/sciadv.1500183
Sonnenburg, E. D., et al. 2016. Diet-induced extinctions in the gut microbiota compound over generations. Nature, vol. 529, pp. 212–215. https://doi.org/10.1038/nature16504
Benbrook, C., Mesnage, R., and Sawyer, W. 2023. Genotoxicity assays published since 2016 shed new light on the oncogenic potential of glyphosate-based herbicides. Agrochemicals, vol. 2, pp. 47-68. https://doi.org/10.3390/agrochemicals2010005
U.S. EPA. 2019. Glyphosate: Response to Comments, Usage, and Benefits. Biological and Economic Analysis Division, EPA, April 18, 2019, pp. 13, 17. https://www.regulations.gov/search?filter=EPA-HQ-OPP-2009-0361-2342.
Benbrook, C.M. 2016. Trends in glyphosate herbicide use in the United States and globally. Environmental Sciences Europe, vol. 28, article no. 3. doi.org/10.1186/s12302-016-0070-0
Gillezeau, C., et al. 2019. The evidence of human exposure to glyphosate: a review. Environmental Health, vol. 18, article no. 2. https://doi.org/10.1186/s12940-018-0435-5 and Soares, D., et al. 2021. Glyphosate use, toxicity and occurrence in food. Foods, vol. 10, article no. 2785. https://doi.org/10.3390/foods10112785 and Vicini J.L., et al. 2021. Residues of glyphosate in food and dietary exposure. Comprehensive Reviews in Food Science and Food Safety, vol. 20, pp. 5226–5257. https://doi.org/10.1111/1541-4337.12822
Battaglin, W.A., et al. 2014. Glyphosate and its degradation product AMPA occur frequently and widely in U.S. soils, surface water, groundwater, and precipitation. Journal of the American Water Resources Association, vol. 50, pp. 275290. https://doi.org/10.1111/jawr.12159
Van Bruggen, A. H. C., et al. 2018. Environmental and health effects of the herbicide glyphosate. The Science of the Total Environment, vol. 616-617, pp. 255–268. doi.org/10.1016/j.scitotenv.2017.10.309
Leino, L., et al. 2020. Classification of the glyphosate target enzyme (5-enolpyruvylshikimate-3-phosphate synthase) for assessing sensitivity of organisms to the herbicide, Journal of Hazardous Materials, vol. 408, article no. 124556. doi.org/10.1016/j.jhazmat.2020.124556
Dechartres, J., et al. 2019. Glyphosate and glyphosate-based herbicide exposure during the peripartum period affects maternal brain plasticity, maternal behaviour and microbiome. Journal of Neuroendocrinology, vol. 31, article no. e12731. DOI: 10.1111/jne.12731 and Lozano, V.L., et al. 2017. Sex-dependent impact of Roundup on the rat gut microbiome. Toxicololgy Reports, vol. 5, pp. 96-107. doi: 10.1016/j.toxrep.2017.12.005.
Mao, Q., et al., 2018. The Ramazzini Institute 13-week pilot study on glyphosate and Roundup administered at human-equivalent dose to Sprague Dawley rats: effects on the microbiome. Environmental Health, vol.17, article no. 50. doi: 10.1186/s12940-018-0394-x.
Dempsey, J. L., et al. 2019. Gut microbiome: An intermediary to neurotoxicity. Neurotoxicology, vol. 75, pp. 41–69. https://doi.org/10.1016/j.neuro.2019.08.005 and Mazuryk J., et al. 2024. Glyphosate: Impact on the microbiota-gut-brain axis and the immune-nervous system, and clinical cases of multiorgan toxicity. Ecotoxicology and Environmental Safety, vol. 271, article no. 115965. doi: 10.1016/j.ecoenv.2024.115965 and Rueda-Ruzafa L, et al. 2019. Gut microbiota and neurological effects of glyphosate. Neurotoxicology, vol. 75, pp. 1-8. doi: 10.1016/j.neuro.2019.08.006
Aitbali, Y., et al. 2018. Glyphosate based-herbicide exposure affects gut microbiota, anxiety and depression-like behaviors in mice. Neurotoxicology and Teratology, vol. 67, pp. 44–49. https://doi.org/10.1016/j.ntt.2018.04.002
Barnett, J. A. and Gibson, D. L. 2020. Separating the empirical wheat from the pseudoscientific chaff: A critical review of the literature surrounding glyphosate, dysbiosis and wheat-sensitivity. Frontiers in Microbiology, vol. 11, article no. 556729. https://doi.org/10.3389/fmicb.2020.556729
Blaser, M. J. 2018. Our missing microbes: Short-term antibiotic courses have long-term consequences. Cleveland Clinic Journal of Medicine, vol. 85, pp. 928–930. https://doi.org/10.3949/ccjm.85gr.18005
Bokulich, N. A., et al. 2016. Antibiotics, birth mode, and diet shape microbiome maturation during early life. Science Translational Medicine, vol. 8, article no. 343ra82. doi:10.1126/scitranslmed.aad7121
Blaser, M. J. 2014. Missing Microbes: How the Overuse of Antibiotics is Fueling Our Modern Plagues. Henry Holt and Company, New York, NY, 273 pp.
Blaser, M. J. 2018. Our missing microbes: Short-term antibiotic courses have long-term consequences. Cleveland Clinic Journal of Medicine, vol. 85, pp. 928–930. https://doi.org/10.3949/ccjm.85gr.18005
Hicks, L.A, Taylor, T.H. Jr, and Hunkler, R.J. 2013. U.S. outpatient antibiotic prescribing, 2010. New England Journal of Medicine, vol. 368, pp. 1461-1462. doi: 10.1056/NEJMc1212055. PMID: 23574140.
Ng, K. M., et al. 2020. Recovery of the gut microbiota after antibiotics depends on host diet, community context, and environmental reservoirs. Cell Host & Microbe, vol. 26, 650-665. https://doi.org/10.1016/j.chom.2020.09.001 and Brodin P. 2022. Immune-microbe interactions early in life: A determinant of health and disease long term. Science, vol. 376, pp. 945–950. https://doi.org/10.1126/science.abk2189
Becattini, S., Taur, Y., and Pamer, E. G. 2016. Antibiotic-induced changes in the intestinal microbiota and disease. Trends in Molecular Medicine, vol. 22, pp. 458–478. https://doi.org/10.1016/j.molmed.2016.04.003
Dubberke, E. R., et al. 2011. The ecology and pathobiology of Clostridium difficile infections: an interdisciplinary challenge. Zoonoses and Public Health, vol. 58, pp. 4–20. https://doi.org/10.1111/j.1863-2378.2010.01352.x
Buddle, J. E., and Fagan, R. P. 2023. Pathogenicity and virulence of Clostridioides difficile. Virulence, vol. 14, article no. 2150452. https://doi.org/10.1080/21505594.2022.2150452
Martin M.J., Thottathil, S.E., and Newman, T.B. 2015. Antibiotics overuse in animal agriculture: A call to action for health care providers. American Journal of Public Health, vol. 105, pp. 2409-2410. https://doi.org/10.2105/ AJPH.2015.302870
Mokdad, A.H., et al. 1999. The spread of the obesity epidemic in the United States, 1991-1998. Journal of the American Medical Association, vol. 282, pp. 1519–1522. doi:10.1001/jama.282.16.1519 and Adult Obesity Prevalence Maps. 2023. Centers for Disease Control and Prevention. National Center for Chronic Disease Prevention and Health Promotion, Division of Nutrition, Physical Activity, and Obesity.
https://www.fda.gov/animal-veterinary/cvm-updates/fda-announces-transition-over-counter-medically-important-antimicrobials-animals-prescription-status Accessed October 2024.
Berendsen, R. L., Pieterse, C. M.J., and Bakker, P. A. H. M. 2012. The rhizosphere microbiome and plant health. Trends in Plant Science, vol. 17, pp. 478–486. 10.1016/j.tplants.2012.04.001
Montgomery, D. and Biklé, A. 2016. The Hidden Half of Nature: The Microbial Roots of Life and Health. W.W. Norton Company, New York, NY, 309 pp.
https://extension.missouri.edu/publications/wq261 Accessed October 2024
Doty, S.L. 2017. Endophytic N-Fixation: Controversy and a Path Forward. In S.L. Doty, ed. Functional Importance of the Plant Endophytic Microbiome: Implications for Agriculture, Forestry, and Bioenergy. Springer Cham., 111 pp. doi. org/10.1007/978-3-319-65897-1_2
Aasfar, A., et al. 2021. Nitrogen fixing Azotobacter species as potential soil biological enhancers for crop nutrition and yield stability. Frontiers in Microbiology, vol., 12, article no. 628379. doi.org/10.3389/fmicb.2021.628379
van der Heijden, M. G. A., et al. 2015. Mycorrhizal ecology and evolution: the past, the present, and the future. The New Phytologist, vol., 205, pp. 1406–1423. doi.org/10.1111/nph.13288
Marschner, H., and Dell, B. 1994. Nutrient uptake in mycorrhizal symbiosis. Plant and Soil, vol. 159, pp. 89–102. www. jstor.org/stable/42939410
Walder, F., et al. 2015. Plant phosphorus acquisition in a common mycorrhizal network: regulation of phosphate transporter genes of the Pht1 family in sorghum and flax. New Phytologist, vol., 205, pp. 1632-1645. doi.org/10.1111/nph.13292
van der Heijden, M. G. A., et al. 2015. Mycorrhizal ecology and evolution: the past, the present, and the future. The New Phytologist, vol., 205, pp. 1406–1423. doi.org/10.1111/nph.13288
Cordell, D., et al. 2009. The story of phosphorus: Global food security and food for thought. Global Environmental Change, vol., 19, pp. 292–305.
Hawkins, H. J., et al. 2023. Mycorrhizal mycelium as a global carbon pool. Current Biology, vol. 33, pp. R560–R573. doi.org/10.1016/j.cub.2023.02.027
Makarewicz, M. et al. 2021. The interactions between polyphenols and microorganisms, especially gut microbiota. Antioxidants, vol. 10, article no. 188. doi.org/10.3390/antiox10020188
Montgomery, D.R. and Biklé, A. 2022. What Your Food Ate: How to Heal Our Land and Reclaim Our Health. W.W. Norton Company, New York, NY, 380 pp.
Montgomery, D.R., et al. 2022. Soil health and nutrient density: Preliminary comparison of regenerative and conventional farming. PEERJ, vol. 10, article no. e12848.
Cordovez, V. et al. 2015. Diversity and functions of volatile organic compounds produced by Streptomyces from a disease-suppressive soil. Frontiers in Microbiology, vol. 6, article no. 1081. doi.org/10.3389/fmicb.2015.01081
Mendes, R., Garbeva, P., and Raaijmakers, J.M. 2013. The rhizosphere microbiome: significance of plant beneficial, plant pathogenic, and human pathogenic microorganisms, FEMS Microbiology Reviews, vol. 37, pp. 634–663. doi. org/10.1111/1574-6976.12028
Poveda, J., and Eugui, D. 2022. Combined use of Trichoderma and beneficial bacteria (mainly Bacillus and Pseudomonas): Development of microbial synergistic bio-inoculants in sustainable agriculture. Biological Control, vol. 176, article no. 105100.
Montgomery, D.R. 2007. Soil erosion and agricultural sustainability. Proceedings of the National Academy of Sciences, vol. 104, pp. 13268-13272. https://doi.org/10.1073/pnas.0611508104
Thaler, E.A., et al. 2021. The extent of soil loss across the US Corn Belt. Proceedings of the National Academy of Sciences, vol. 118, article no. 1922375118. doi.org/10.1073/pnas.1922375118
Jansa, J., Wiemken, A., and Frossard, E. 2006. The effects of agricultural practices on arbuscular mycorrhizal fungi. Geological Society, London, Special Publications, vol. 266, pp.89-115.
Weil, R. and Brady, N. 2017. The Nature and Properties of Soils, 15th Edition. Pearson Press, 1,086 pp.
Egan, F. and Nawa, S.B. 2021. Soil Health Benchmarks: 2021 Report. Pasa Sustainable Agriculture. https://pasafarming.org/wp-content/uploads/2021/03/Soil-Health-Benchmarks-Report-2021_Digital_Compressed.pdf.
Fan, K., et al. 2019. Suppressed N fixation and diazotrophs after four decades of fertilization. Microbiome, vol. 7, article no. 143. doi.org/10.1186/s40168-019-0757-8
Khan, S.A., et al. 2007. The myth of nitrogen fertilization for soil carbon sequestration. Journal of Environmental Quality, vol. 36, pp. 1821-1832. https://doi.org/10.2134/jeq2007.0099
Williams, A., et al. 2017. Long-term agricultural fertilization alters arbuscular mycorrhizal fungal community composition and barley (Hordeum vulgare) mycorrhizal carbon and phosphorus exchange. New Phytologist, vol. 213, pp. 874-885. https://doi.org/10.1111/nph.14196
Niewiadomska, A. and Sawicka A. 2002. Effect of carbendazim, imazetapir and thiram on nitrogenase activity, number of microorgansisms in soil and yield of hybrid lucerne (Medicago sativa). Polish Journal of Environmental Studies, vol. 11, pp.737-744.
Mulvaney, R. L., Khan, S. A., and Ellsworth, T. R. 2009. Synthetic nitrogen fertilizers deplete soil nitrogen: a global dilemma for sustainable cereal production. Journal of Environmental Quality, vol. 38, pp. 2295–2314. https://doi. org/10.2134/jeq2008.0527
NRCS. 2006. Model simulation of soil loss, nutrient loss, and change in soil organic carbon associated with crop production, Natural Resources Conservation Service, U.S. Dept. of Agriculture, June 2006.
NRCS. 2007. Nitrogen Efficiency and Management. Natural Resources Conservation Service, U.S. Dept. of Agriculture, 2017.
Greer, F. R. and Shannon, M. 2005. American Academy of Pediatrics Committee on Nutrition, & American Academy of Pediatrics Committee on Environmental Health. Infant methemoglobinemia: the role of dietary nitrate in food and water. Pediatrics, vol. 116, pp. 784–786. https://doi.org/10.1542/peds.2005-1497 and Sherris, A. R., et al. 2021. Nitrate in drinking water during pregnancy and spontaneous preterm birth: A retrospective within-mother analysis in California. Environmental Health Perspectives, vol. 129, article no. 057001. https://doi.org/10.1289/EHP8205
NRCS. 2006. Model simulation of soil loss, nutrient loss, and change in soil organic carbon associated with crop production, Natural Resources Conservation Service, U.S. Dept. of Agriculture, June 2006.
Diaz, R. J. and Rosenberg, R. 2008. Spreading dead zones and consequences for marine ecosystems. Science, vol. 321, pp. 926–929. https://doi.org/10.1126/science.1156401
Mulvaney, R. L., Khan, S. A., and Ellsworth, T. R. 2009. Synthetic nitrogen fertilizers deplete soil nitrogen: a global dilemma for sustainable cereal production. Journal of Environmental Quality, vol. 38, pp. 2295–2314. https://doi. org/10.2134/jeq2008.0527
Khan, S.A., et al. 2007. The myth of nitrogen fertilization for soil carbon sequestration. Journal of Environmental Quality, vol. 36, pp. 1821-32. doi: 10.2134/jeq2007.0099
Martinez, D.A., et al. 2021. When the medicine feeds the problem; Do nitrogen fertilisers and pesticides enhance the nutritional quality of crops for their pests and pathogens? Frontiers in Sustainable Food Systems, Vol. 5, Article no., 701310. doi.org/10.3389/fsufs.2021.701310
Kremer, R.J. and Means, N.E. 2009. Glyphosate and glyphosate-resistant crop interactions with rhizosphere microorganisms. European Journal of Agronomy, vol. 31, pp. 153-161. doi:10.1016/j.eja.2009.06.004 and Zobiole, L. H., et al. 2011. Glyphosate affects micro-organisms in rhizospheres of glyphosate-resistant soybeans. Journal of Applied Microbiology, vol. 110, pp. 118–127. https://doi.org/10.1111/j.1365-2672.2010.04864.x
Lupwayi N.Z., et al. 2009. Soil microbial response to herbicides applied to glyphosate-resistant canola. Agriculture, Ecosystems and Environment, vol. 129, pp. 171- 176. https://doi.org/10.1016/j.agee.2008.08.007
Zablotowicz, R.M. and Reddy, K.N. 2004. Impact of glyphosate on the Bradyrhizobium japonicum symbiosis with glyphosate-resistant transgenic soybean: a minireview. Journal of Environmental Quality, vol. 33, pp. 825-831.
King, A.C., Purcell, L.C., and Vories, E.D. 2001. Plant growth and nitrogenase activity of glyphosate-tolerant soybean in response to foliar glyphosate applications, Agronomy Journal, vol. 93, pp. 179-186.
Zobiole, L. H., et al. 2010. Effect of glyphosate on symbiotic N2 fixation and nickel concentration in glyphosate-resistant soybeans. Applied Soil Ecology, vol. 44, pp. 176-180. doi:10.1016/j.apsoil.2009.12.
Mertens, M., et al. 2018. Glyphosate, a chelating agent-relevant for ecological risk assessment? Environmental Science and Pollution Research International, vol. 25, pp. 5298–5317. https://doi.org/10.1007/s11356-017-1080-1
Fernandez, M.R., et al. 2009. Glyphosate associations with cereal diseases caused by Fusarium spp. in the Canadian Prairies. European Journal of Agronomy, vol. 31, pp.133-143. https://doi.org/10.1016/j.eja.2009.07.003
Kurenbach, B., et al. 2015. Sublethal exposure to commercial formulations of the herbicides dicamba, 2,4-dichlorophenoxyacetic acid, and glyphosate cause changes in antibiotic susceptibility in Escherichia coli and Salmonella enterica serovar Typhimurium. mBio, vol. 6, article no. e00009-15. doi.org/10.1128/mBio.00009-15
Liao, H., et al. 2021. Herbicide selection promotes antibiotic resistance in soil microbiomes. Molecular Biology and Evolution, vol. 38, pp. 2337–2350. doi.org/10.1093/molbev/msab029
Ahmad, M. F., et al. 2024. Pesticides impacts on human health and the environment with their mechanisms of action and possible countermeasures. Heliyon, vol. 10, article no. e29128. https://doi.org/10.1016/j.heliyon.2024.e29128
